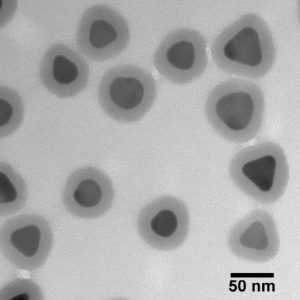

Silver nanoplates are platelet-shaped nanoparticles that have extremely large absorbing and scattering cross-sections in the visible and near-IR regions of the spectrum.
The standard (silanol) silica surface on our silica shelled nanoplates increases stability in a wide range of solvents.
NanoXact materials are high quality, unagglomerated and monodisperse nanoparticles.
Peak Wavelength & Diameter
Peak λ 660 nm · 80 nm diameter (40 nm core with 20 nm shell)
Peak λ 800 nm · 100 nm diameter (60 nm core with 20 nm shell)
Peak λ 980 nm · 140 nm diameter (100 nm core with 20 nm shell)
Peak λ 1064 nm · 190 nm diameter (150 nm core with 20 nm shell)
Concentration
1 mg/mL in 10 mM sodium bicarbonate
Select Volume
1 mL5 mL10 mL30 mL
+91-8800903073, 8452810712